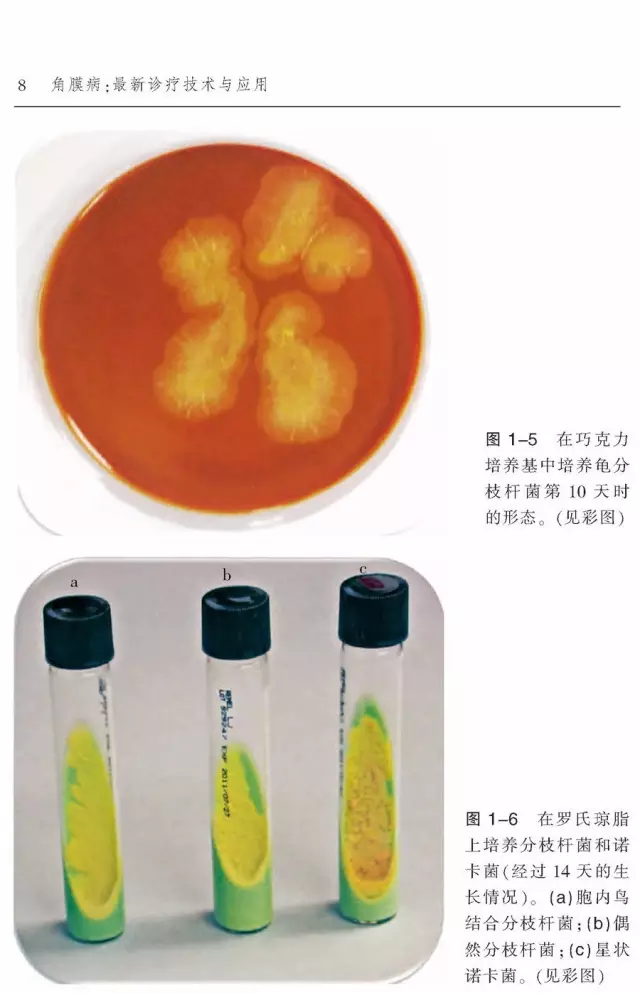

商品详情

132页 ,国际32开,铜板纸印刷
2014年6月 定价:48.00 元
价值·特点
书中所介绍的专科技术和专业知识超前、新颖、实用,这是本书最大的特点。同时,这本书的读者对象广,可以是需要了解角膜病研究进展的眼科学专家,也可以是研究生以及住院和进修医师,对广大眼科医生的临床实践具有很强的指导作用!
内容介绍
本书详细介绍了角膜疾病诊疗的最新进展,多是目前我国教科书未涉及的内容。如细菌性角膜炎的抗菌药物治疗指南非常实用和系统;还详细介绍了共聚焦显微镜和OCT影像技术在角膜疾病诊断和屈光手术及角膜移植方面的新应用;在眼库方面,介绍了眼库制备的内皮供体材料对于满足不断增长的内皮角膜移植手术需求的至关重要性。
作者简介
(德)托马斯·莱因哈德,是弗莱伯大学眼科医院的主席,德国眼科委员会委员,并在2010-2011年间担任其高级顾问。擅长角膜病的诊断和治疗,包括片层和全层角膜移植术。
(英)弗兰克-拉金,2001至2008年为皇家Moorfields眼科医院角膜和外部疾病服务部主任,自2009年以来一直为EuCornea的董事会成员。
译者介绍
陈蔚,教授,主任医师,医学博士。目前担任中华眼科学会角膜病学组委员,亚洲干眼学会创始会员,亚洲角膜病学会会员,温州医科大学附属眼视光医院角膜病中心主任,兼任白内障中心主任,温州市眼库副主任,国家自然科学基金评审专家。中华眼视光和视觉科学杂志编委,ophthalmology中文版编委。
目 录目 录
第1章 分枝杆菌性角膜炎诊断和治疗的新进展
第2章 细菌性角膜炎抗菌药物治疗新进展
第3章 圆锥角膜的遗传学研究
第4章 角膜影像技术的进展
第5章 角膜抗新生血管治疗方法的选择
第6章 穿透性和板层角膜移植术的供体角膜储存
第7章 婴幼儿角膜移植
索引
内文预览部分及章节

检索+彩插
关于物流:下单后,2个工作日发货,请大家不要着急。本次活动由 天津科技翻译出版有限公司 直接发货,默认中通和汇通快递。
关于发票:需要发票的老师请在购书时留言,填写发票信息(不再补寄)。
客服QQ:21294643
电话:022-87893482 / 87894896
眼科专场大优惠,合计付款不足78元的加收5元运费,新疆’西藏加收10元,满合计付款78元的,全国包邮。
- 天津科技翻译出版 (微信公众号认证)
- 为作者、译者,及读者服务
- 扫描二维码,访问我们的微信店铺
- 随时随地的购物、客服咨询、查询订单和物流...